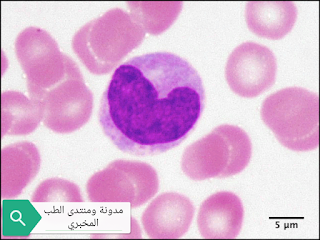

خلایا الدم البیضاء:
تعتبر البیضاوات في الدم كخلایا غیر نشطة نسبیاً ، اذ ان الدم لھا مجرد وسیلة للانتقال و لكنھا كثیراً ما تغادر تلك الاوعیة بواسطة الحركة الامیبیة و خاصیة الانسلال خلال الجدار الوعائي لتصل الى الانسجة الضامة المحیطة بھذه الاوعیة الدمویة وھناك یتسنى لھا القیام بعدد من الأعمال ( الوظائف ) الخاصة بھا .وتختلف الخلایا البیضاء بعدم وجود الھیموجلوبین ولكنھا تتمیز عنھا بوجود نواه وفي الحقیقة فإن اللون الأصلي لھذه الخلایا یعتبر شفافاً لكنه نتیجة لانعكاس الضوء فھم یظھروا تحت المجھر باللون الأبیض. ویبلغ عددھا من ٤٠٠٠ إلى ١٠ آلاف في المللیمتر المكعب من الدم.
* أنواع الخلایا البیضاء في الدم:
یمكن تمییز خمسة أنواع من الخلایا البیضاء تحت المجھر وھذا التمییز یعتمد على شكل النواة وأقسامھا وعلى نوع الصبغة التي تكتسبھا الخلیة.أ ـ خلایا محببة Granular وتشمل:
☜ خلایا Neutrophil :
وتمثل حوالي ٦٠ %من العدد الكلي تكتسب صبغة حمراء.
☜ خلایا Eosinophil :
وتمثل حوالي ١ ـ ٣ %من العدد الكلى ـ تكتسب صبغة زرقاء.
☜ خلایا Basophil :
وتمثل من ٠ ـ ١ % من العدد الكلي.
ب - خلایا غیر محببة Agranular :
☜ خلایا lymphocyte :
وتمثل حوالي ٢٠ ـ ٤٥ .%
ــ☜ monocyte :
وتمثل حوالي ١ - ٨ %
* اماكن تكوین خلایا الدم البیضاء:
أ ـ الخلایا المحببة Granular:
⇦ تتكون في نخاع العظام الأحمر.
ب ـ الخلایا غیر المحببة Agranular:
⇦ تتكون في الأنسجة اللیمفاویة كالطحال والكبد والغدد اللیمفاویة.
* مدة حیاة خلایا الدم البیضاء:
☜ ھي قصیرة جداً إذا قورنت بخلایا الدم فعمرھا حوالي بضع ساعات في حالة الخلایا اللیمفاویة ومن یوم إلى یومین في باقي الخلایا البیضاء، والخلایا البیضاء عادة ما تغادر الجھاز الدوري لتقوم بوظائفھا بالأنسجة.
* التغییر في عدد خلایا الدم البیضاء:
🅰 ـ یزید عددھا في الأطفال والحوامل وجمیع الأمراض الحادة مثل الالتھاب الرئوي.
🅱 ـ ویقل عددھا في حالات الأمراض المزمنة كالتیفود وفي المجاعة وسوء التغذیة.
1⃣ Neutrophils
الخلایا المتعادلة او العدلة
- تعد أكثر الكریات البیض انتشارا في الدورة الدمویة (٤٠ - ٧٠) %
- تملك نواة مفصصة Segmented، عادة بین ٣إلى ٥ فصوص موصولة ببعضھا بواسطة شریط رفیع من الكروماتین وقد تكون متصلة band .
- تملك حبیبات أولیة primary granule تظھر باللون البنفسجي والتي ھي عبارة عن جسیمات حالة تحوي acid hydrolase وmyeloperoxidase .
- تملك حبیبات ثانویة تحوي lactoferrin,lysosome،فوسفات
قلویة،ومواد قاتلة ومقاومة للبكتریا.
- ھي أول من یصل إلى مكان تضرر النسیج(خلال ٣٠ دقیقة ).
- لھا دور أساسي في بلعمة البكتریا والخلایا المیتة وتستخدم مستقبلات الضد، عوامل المتممة، وعدیدات السكرید التابعة للبكتریا للارتباط بالمواد الاجنبیة.
- تلعب دورا ھاما في المناعة الخلقیة إلى جانب البالعات وال Natural killer celle
✳ اما خصائص ھذه الخلایا (Neutrophils) الوظیفیة فھي :
1- الانسلال Diapedesis :
وھي ھجرة النیتروفیل الموجود في الدم من خلال جدران الاوعیة الدمویة الى الانسجة .
2- الحركة الامیبیة :
و بواسطتھا یتم تبادل النیتروفیل بین الدم و الانسجة الضامة الاخرى ، وعند اللزوم و الاستعداد كما یحدث في الالتھابات فإن النیتروفیل تھاجر بـ اعداد كبیرة الى المكان و تعرف ھذه العملیة باسم الانسلال Diapedesis وكذلك تتحرك النیتروفیل داخل الانسجة بھذه الحركة للقیام بعملھا الاساسي وھو البلعمة .
3- خاصیة الجذب Chemotaxis :
وھي عبارة عن تحرك العدلة نحو المواد الكیمیائیة التي تفرز من الجراثیم .
4- البلعمة او الالتھام Phagocytosis :
تلتھم النیتروفیل العناصر الغریبة عنھا في الجسم و تدخلھا الى جسمھا بحركة سیتوبلازمھا و اھم ھذه الاجسام ھي البكتیریا ، فعندما تغزو البكتیریا انسجة ما فإن النیتروفیل یزداد عددھا في الدم و الانسجة و تقوم بالتھام البكتیریا و تحطیمھا بواسطة انزیمات لیسوسوماتھا التي تنفجر مسببة موت Neutrophils وفي نفس الوقت موت البكتیریا ، و تكدس الخلایا المیته ھو الذي یكوّن الصدید pus ( القیح ).
5 - الافراز
تفرز النیتروفیل بعض الإنزیمات والتي لھا علاقة بعملیة البلعمة مثل الإنزیمات الضروریة لھضم المواد المبتلعة والانسجة لھضم المواد المبتلعة ، وكما تفرز بعض المواد الاخرى مثل Transcobolamin و Globulin والتي تثبت و تحمل فیتامین ب12 في البلازما والتي لھا علاقة ببعض امراض الدم فمثلاً في احمرار الدم تزداد ال Transcobolamin، وھذا یعني ان لھا علاقة بعدد الخلایا النیتروفیل في الدم فعند زیادته تزداد ھذه المواد وعندما ینقص عددھا تنقص كمیة ھذه المواد
⇧⇧ الزیادة في عدد الخلایا المتعادلة تسمى بـ Neutrophilia:
1 -أسباب أو حالات غیر مرضیة (الاطفال حدیثي الولادة / المجھود العضلي الشدید / أثناء الشھور الأخیرة من الحمل / التوتر العصبي).
2 -أسباب أو حالات مرضیة مثل:
✪ حالات التسمم (تسمم داخلي مثل البولینا/تسمم خارجي بالرصاص او الكورتیزون او اول اكسید الكربون).
✪ العدوى العامة مثل الدفتیریا والالتھاب الرئوي.
✪ الاورام السرطانیة ، وسرطان الدم الابیض غیر اللیمفاوي.
✪ التھاب اللوز والتھاب الزائدة الدودیة.
✪ النزیف الشدید.
⇩⇩ الانخفاض في عدد الخلایا المتعادلة یسمى بـ Neutropenia:
☆ العدوى بالامراض الفیروسیة مثل الحصبة والانفلونزا.
☆ الحمى التیفودیة fever Typhoid / الحمى المالطیة Brucellosis.
☆ مرض الدرن المتسبب عن البكتریا.
☆ فقر الدم الناتج عن نقص فیتامین B12 ونقص حامض الفولیك.
☆ ھبوط في نشاط النخاع العظمي بسبب التعرض للإشعاع أو الاصابة بالأورام المتعددة.
☆ السموم التي تؤدي إلى ھبوط في النخاع العظمي مثل الزرنیخ وأدویة السلفا ، البنزین.
☆ الأدویة وھي السبب في معظم الحالات ومن أشھر ھذه الأدویة مایلي :
☜ مضاد الغدة الدرقیة / مضاد الصرع / مضاد السكري / مضاد التخثر / مضادة الھستامین / مضادة الملاریا / مضادة الدرن / وبعض من المضادات الحیویة.
2⃣ Eosinophil
- تشكل ٥ %من خلایا الدم البیضاء في الدوران المحیطي.
- تحوي نواة مفصصة(مؤلفة من فصین).
- تحوي حبیبات محبة للحامض لونھا احمر تشبھ حب الرمان وھي اكبر واكثر كثافة من الموجودة على النیتروفیل وھي :
➢ Major basic protein
➢ acid hydrolases
➢ peroxidase
- تحوي مستقبلات الIge
- تلعب دورا في infection parasitic
- تخفف من شدة رد الفعل المناعي في الجسم حیث تفرز
الھیستامیناز (والذي یحطم الھیستامین المفرز من الخلایا البدینة ) والبروستاغلاندین e2 ,e1 الذي یثبط إفراز الخلایا البدینة.
اما خصائص ھذه الخلایا الوظیفیة فھي :
1- له علاقة مباشرة بالحساسیة لھذا یعتقد انه یمتص الھستامین الناتج عن حالات الحساسیة و كذلك یمنع تأثیر المواد السامة و البروتینات الغریبة التي تدخل الجسم .
2- له دور في تجلط الدم : یعتقد انه یفرز مادة تسمى Plasminogen او Profibrin olysin التي تتحول الى
ــFibrinolysin والتي تعتبر انزیم یعمل على ھضم اللیفن من الدم المتخثر .
3-له دور بسیط في عملیة البلعمه .
⇧⇧ الزیادة في عدد الخلایا الحامضیة یعرف بـ
:Eosinophila .
☜ الأصابة بالطفیلیات مثل البلھارسیا، والانكلستوما، والملاریا.
☜ الأمراض الجلدیة مثل الاكزیما والصدفیة والجرب وغیره.
☜ أمراض الحساسیة مثل الربو الشعبي.
☜ سرطان الدم غیر اللیمفاوي المزمن.
☜ تعاطي بعض الادویة مثل البنسلین.
☜ الأورام الخبیثة.
⇩⇩الانخفاض في عدد الخلایا الحامضیة یعرف بـ Eosinopenia:
⇦ حالات الضغوط Stress / الصدمة Shock / والحروق Burns.
⇦ تناول علاج الكورتیزون.
⇦ بعد العملیات الجراحیة.
3⃣ Basophils
- حوالي ٠٫٥ %من خلایا الكریات البیضاء
- النواة مؤلفة من ٢ الى ٣ فصوص ولكن النواة صعبة التمییز بسبب اللون الاساسي الطاغي على كل الخلیة.
- تحوي حبیبات محببة تظھر باللون الازرق الغامق تحوي:
ھستامین
ھیبارین
ھدروكسي تریبتامین (مضیق أوعیة)
sulfated proteog
lycans
☜ تملك مستقبلات IGE
- تلعب Basophils دورا في تفاعل فرط التحسس ،بعض أنواع الربو، urticaria ،وanaphylaxis
اما خصائص ھذه الخلایا الوظیفیة فھي :
١ - تكوین الھیبارین و تحرره داخل الدم الذي یمنع تخثر الدم وكذلك یحرر الدھون من الدم .
٢ - له علاقة مباشرة بالحساسیة فھو ینتج او یمتص الھستامین .
- لا علاقة لة بالبلعمة .
⇧⇧ الزیادة في عدد الخلایا القاعدیة یعرف بـ
➢Basophilia
☜ سرطان الدم الأبیض المزمن.
☜ ھبوط نشاط الغدة الدرقیة.
☜ بعد عملیة استئصال الطحال.
⇩⇩ الانخفاض في عدد الخلایا القاعدیة یعرف بـ
➢ Basopenia
☜ زیادة نشاط الغدة الدرقیة.
☜ الالتھابات الحادة.
☜ العلاج بالكورتیزون.
4⃣ الخلایا اللیمفاویة (Lymphocytes)
والخلایا اللیمفاویة من وظائفھا قتل الفیروسات وتنظیم الجھاز المناعى ككل بجسم الإنسان، حیث تتعرف الخلایا اللیمفاویة على أیة أجسام غریبة تغزو أو تھاجم جسم الإنسان وتزید من مقاومة الجسم للعدوى.
وتنقسم الخلایا اللیمفاویة أیضاً إلى عدة أنواع:
🅰- الخلایا اللیمفاویة "بى" (B :(وھى التى تفرز أجسام مضادة ضد البكتریا والفیروسات.
🅱- الخلایا اللیمفاویة "تى" (T :(والتى لھا دور فى التعرف على جمیع الأجسام الغریبة على الجسم.
وظائف الخلایا اللمفاویة
١ - تكوین مضادات المناعة Antibodies ویمكن ان یتحول الى Plasma cell التي ھي الجزء
الرئیسي لانتاج ھذه المضادات .
٢ - یمكن بدخولھا من الدم الى الانسجة ان تتحول الى خلایا بلعمیة كبیرة والتي لھا القدرة على البلعمة و لكن ھي نفسھا لیس لھا القدرة على ذلك .
٣- تكوین ھرمون المنشط للغدة الدرقیة ، الذي یعمل مثیراً او منشطاً للغدة الدرقیة .
٤ــ DNA الموجود في نواة الخلیة اللمفاویة المیتة ممكن استخدامه في خلیة اخرى .
٥ - تحتوي ھذه الخلایا على خمیرة حاله للشحوم
⇧⇧الزیادة في عدد خلایا الدم البیضاء اللیمفاویة تعرف بـ
➢Lymphocytosis
☜ بعض حالات العدوى عند لأطفال مثل الحصبة والانفلونزا
والسعال الدیكي.
☜ الحمى التیفودیة والحمى والمالطیة.
☜ التھاب الكبد الفیروسي Viral hepatitis
☜ التھاب الغدد اللیمفاویة.
☜ سرطان الدم اللیمفاوي.
⇩⇩ الانخفاض في عدد خلایا الدم البیضاء اللیمفاویة یعرف بـ
➢Lymphocytopenia
☜ تناول بعض الأدویة مثل مضادات السرطان.
☜ حالات التسمم بالبولینا الحاد أو المزمن.
☜ تناول علاج الكورتیزون.
☜ التعرض للإشعاع.
5⃣ Monocyte
الخلايا الأحادية
- تشكل من ١ إلى ٧ % من الكریات البیض
- تشكل قسما من نظام خلیة وحیدة - خلیة بالعة macrophage- monocyte system والذي یحوي:
☜أ- خلایا كوبفر ( Kupffer cells) في الكبد
☜ ب-البالعات macrophage .
☜ ج- الخلایا الناسجة histocyte في النسیج الضام.
☜ د- الخلایا الدبیقیة Microglia في الدماغ.
☜ ه- خلایا لانغرھانس في الجلد.
☜و-الخلایا الكاسرة للعظم في العظم.
یؤدي وجود الخلایا المیتة أو المیكروبات أو الإلتھاب إلى ھجرة ھذه الخلایا من الاوعیة الدمویة لتدخل في الانسجة وتسمى عندئذ بالبالعات macrophage .
اما خصائص ھذه الخلایا الوظیفیة فھي :
- البلعمه : تترك دائماًالدم الى الانسجة عن طریق الحركة الامیبیة فتتحول الى خلایا بلعمیة كبیرة macrophages تلتھم الاجسام الغریبة . قتل الجراثیم مثل الدرن (Tuberculosis )
- تساعد على اعادة بناء الانسجة المحطمة بعد الالتھابات .
⇧⇧ الزیادة في عدد الخلایا وحیدة النوة یعرف
بـ Monocytosis:
☜ العدوى بالبكتریا مثل بكتریا الدرن B.T أو التیفوید او الحمى
المالطیة.
☜ الإصابة بالطفیلیات وحیدة النواة مثل الملاریا Malaria.
-☜الالتھابات وتقرح القولون المزمن.
☜بعض الأورام.
⇩⇩الانخفاض في عدد الخلایا وحیدة النواة یعرف بـ
➢ Monocytopenia
نقص فیتامین B12 وحمض الفولیك.
☜ سرطان الدم Leukemia.
☜ تلیف النخاع العظمي Aplastic anaemia
* اختبار عد خلايا الدم البيضاء count WBC
• الأدوات المستخدمة:
1ـ جھاز الھيموسيتومتر ( Haemocytometer )
2ـ عينة دم تكون موضوعة في مادة مانعة للتجلط (EDTA).
3ـ محلول ( 2 %حامض الستريك + 1 %محلول مائي الأزرق الميثلين).
4ـ ورق ترشيح.
طريقة العمل:
1ـ نقوم بسحب الدم بواسطة الماصة ذات الخرزة البيظاء من عينة الدم حتى العلامة . 0.5.
2ـ إذا حصل أي ارتفاع في مستوى الدم عن العالمة 0.5 نقوم بسحب الزائد من الدم بواسطة ورق الترشيح مع مراعاة خلو الماصة من الفقاعات الھوائية.
3ـ نقوم بسحب المحلول حتى العالمة 11 مع مراعاة عدم تكون أي فقاعات هواء داخل الانبوب وتنظيف مقدمة الماصة بواسطة ورق الترشيح.
4ـ نقوم بسحب الماصة المطاطية ونقوم برج الانبوب برفق حتى نقوم بخلط الدم مع المحلول وتتم عملية المزج فترة 2 دقيقة.
5ـ يتم التخلص من أول قطرتين من محتويات الماصة برفق.
6ـ نقوم بوضع قطرة على شريحة العد ثم نقوم بوضع غطاء شريحة العد ثم نقوم بالعد في مربعات العد الأبيض.
7ـ لابد من جفاف شريحة العد ونظافتھا وغطاء الشريحة.
يجب التأكد من عدم وجود فقاعات تحت شريحة العد وكذلك تجانس المحلول تحت الغطاء.
طريقة حساب خلايا الدم البيضاء:
(عدد خلايا الدم البيضاء في المربعات الأربعة÷ 4 )×10× 20 =ملم3
او
WBCs/L = No. ×50×10^6
• المعدل الطبيعي لكريات الدم البيضاء(WBC)
ــ 4000 – 11000 خلية / ملم3 .
:Prepared by
.Dr. Tareq Quleh

ليست هناك تعليقات:
إرسال تعليق
ملحوظة: يمكن لأعضاء المدونة فقط إرسال تعليق.